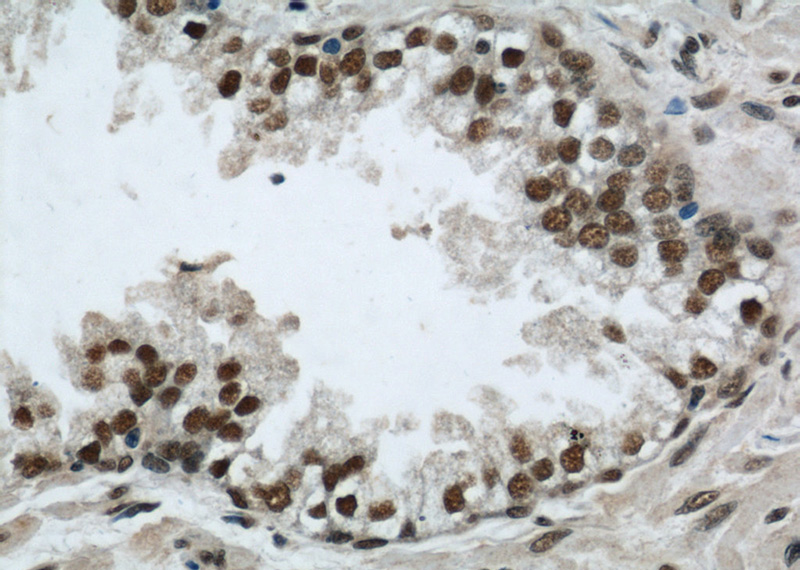
Immunohistochemistry of paraffin-embedded human prostate cancer slide using Catalog No:114259(PTBP1 Antibody) at dilution of 1:50

-
Product Name
PTBP1 antibody
- Documents
-
Description
PTBP1 Rabbit Polyclonal antibody. Positive WB detected in Jurkat cells, BxPC-3 cells, HeLa cells, human lung tissue, K-562 cells, mouse lung tissue, rat heart tissue. Positive IHC detected in human prostate cancer tissue, human pancreas tissue. Positive IF detected in A2780 cells. Observed molecular weight by Western-blot: 59.6kd
-
Tested applications
ELISA, WB, IF, IHC
-
Species reactivity
Human,Mouse,Rat; other species not tested.
-
Alternative names
HNRNP I antibody; HNRNPI antibody; HNRPI antibody; pPTB antibody; PTB antibody; PTB 1 antibody; PTB T antibody; PTB2 antibody; PTB3 antibody; PTB4 antibody; PTBP1 antibody
-
Isotype
Rabbit IgG
-
Preparation
This antibody was obtained by immunization of PTBP1 recombinant protein (Accession Number: NM_002819). Purification method: Antigen affinity purified.
-
Clonality
Polyclonal
-
Formulation
PBS with 0.1% sodium azide and 50% glycerol pH 7.3.
-
Storage instructions
Store at -20℃. DO NOT ALIQUOT
-
Applications
Recommended Dilution:
WB: 1:1000-1:10000
IHC: 1:20-1:200
IF: 1:10-1:100
-
Validations

Jurkat cells were subjected to SDS PAGE followed by western blot with Catalog No:114259(PTBP1 antibody) at dilution of 1:400
Immunohistochemistry of paraffin-embedded human prostate cancer slide using Catalog No:114259(PTBP1 Antibody) at dilution of 1:50

Immunofluorescent analysis of A2780 cells, using PTBP1 antibody Catalog No:114259 at 1:25 dilution and Rhodamine-labeled goat anti-rabbit IgG (red).
-
Background
Polypyrimidine tract-binding protein (PTBP1), also known as heterogeneous nuclear ribonucleoprotein type I (hnRNP I), is a nuclear protein that binds pre-mRNAs in specific regions of the hnRNA-protein complexes sensitive to micrococcal nuclease. It involves in pre-mRNA splicing and the regulation of alternative splicing events. PTBP1 promotes RNA looping when bound to two separate polypyrimidine tracts in the same pre-mRNA, and promotes the binding of U2 snRNP to pre-mRNA. Besides, it can cooperate with RAVER1 to modulate switching between mutually exclusive exons during maturation of the TPM1 pre-mRNA, and represses the splicing of MAPT/Tau exon 10
-
References
- Guo R, Li Y, Ning J, Sun D, Lin L, Liu X. HnRNP A1/A2 and SF2/ASF regulate alternative splicing of interferon regulatory factor-3 and affect immunomodulatory functions in human non-small cell lung cancer cells. PloS one. 8(4):e62729. 2013.
- Gallagher IJ, Scheele C, Keller P. Integration of microRNA changes in vivo identifies novel molecular features of muscle insulin resistance in type 2 diabetes. Genome medicine. 2(2):9. 2010.
- Markus MA, Marques FZ, Morris BJ. Resveratrol, by modulating RNA processing factor levels, can influence the alternative splicing of pre-mRNAs. PloS one. 6(12):e28926. 2011.
Related Products / Services
Please note: All products are "FOR RESEARCH USE ONLY AND ARE NOT INTENDED FOR DIAGNOSTIC OR THERAPEUTIC USE"
